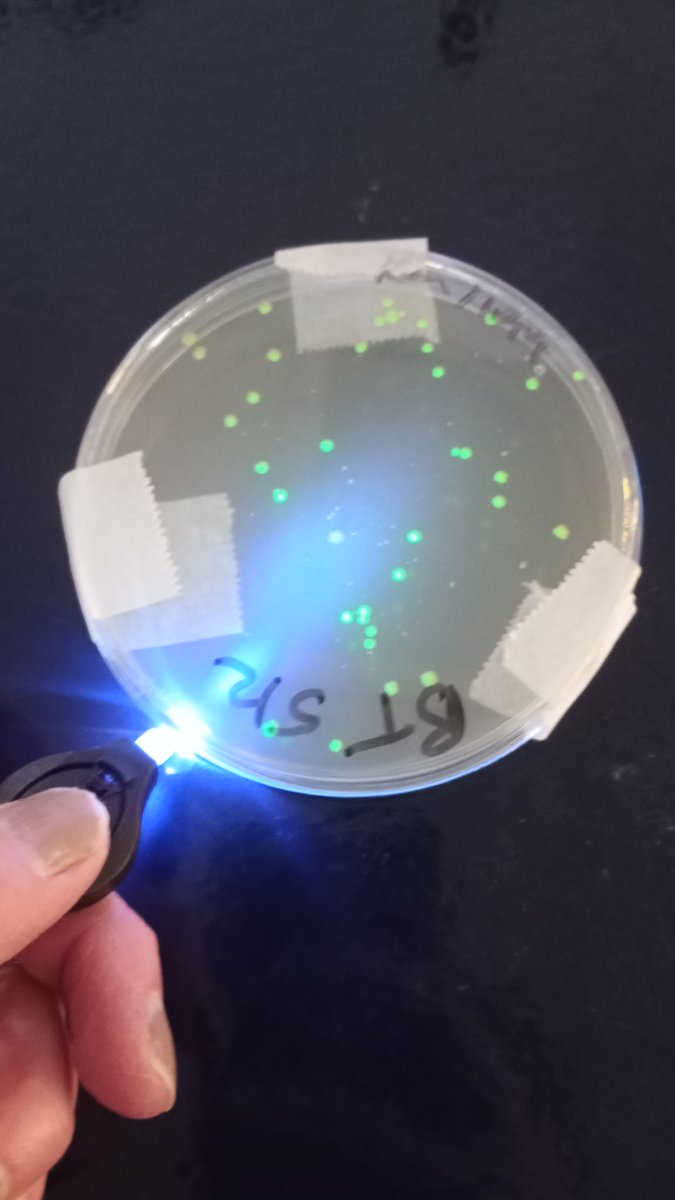
National Centre for Biotechnology Education tweet media

It’s that time of year again, when students make bacteria fluoresce!
Bacterial transformations are a brilliant way to practise aseptic technique and explore how plasmids carry genes like antibiotic resistance.
See our video for the best results: youtu.be/vli2ZJdhonw

YouTube

English